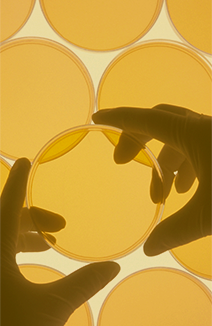
Objetivo 1b1: Reforçar o funcionamento sinérgico e em rede da I+I a nível transnacional nos setores específicos do Sudoe a partir da especialização inteligente

Está aberta a segunda Convocatória!









Objetivo 6d: Reforçar a cooperação dos gestores de espaços naturais do SUDOE através do desenvolvimento e implementação de métodos conjuntos

Objetivo 1b1: Reforçar o funcionamento sinérgico e em rede da I+I a nível transnacional nos setores específicos do Sudoe a partir da especialização inteligente


Objetivo 5b Melhoria da coordenação e da eficácia dos instrumentos de prevenção, de gestão de catástrofes e de reabilitação de zonas danificadas




